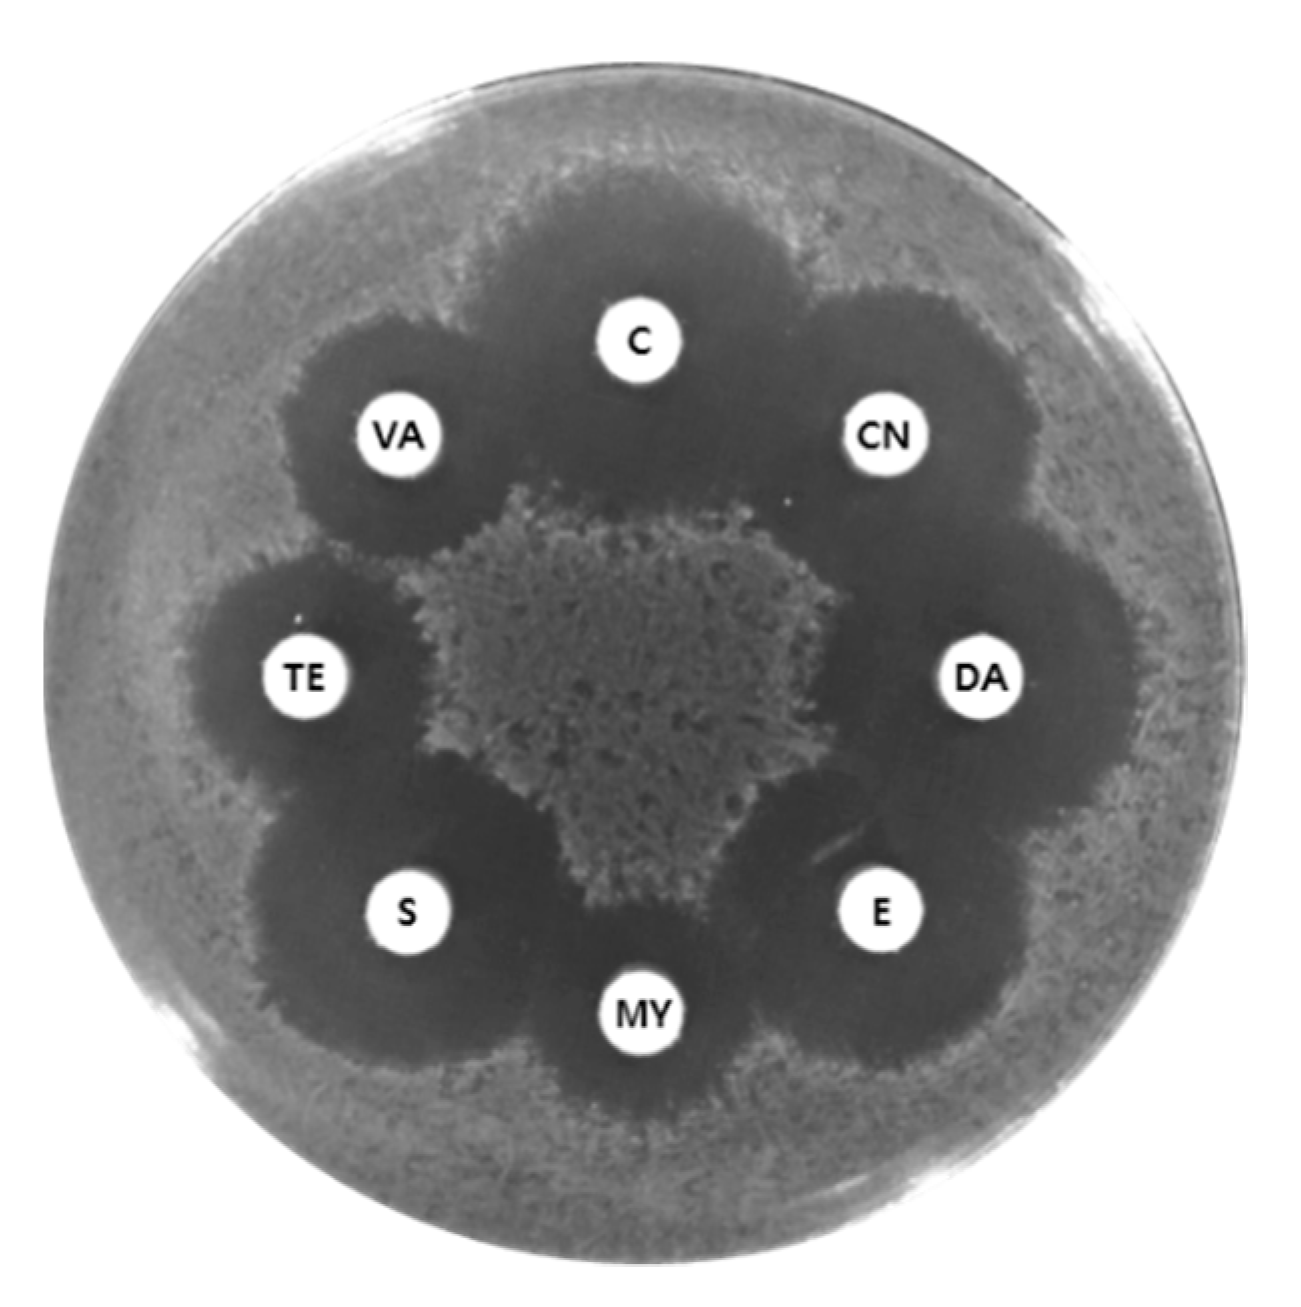

Functional Annotation Genome Unravels Potential Probiotic Bacillus velezensis Strain KMU01 from Traditional Korean Fermented Kimchi
Abstract
1. Introduction
2. Materials and Methods
2.1. Bacterial Strains and Culture Conditions
2.2. Genome Sequencing
2.3. Comparative Genomics
2.4. Multilocus Sequence Typing and Phylogenetic Analysis
2.5. PCR for the Identification of Toxin Determinants
2.6. Hemolytic Activity Tests
2.7. Antibiotic Susceptibility Test
2.8. Growth Monitoring in the Presence of NaCl
2.9. Determination of Antibacterial Activity
2.10. Determination of Salt Tolerance, Acid Production, and Enzymatic Activity
2.11. Nucleotide Sequence Accession Number
3. Results and Discussion
3.1. Genetic Identification of Bacillus velezensis KMU01
3.2. General Genome Properties of Strain KMU01
3.3. Safety Properties of Strain KMU01
3.3.1. Enterotoxin
3.3.2. Transferrable Antibiotic Resistance
3.4. Functional Properties of the Strain KMU01 Genome
3.4.1. Survival of Strain KMU01 in High-Salt Conditions
3.4.2. Probiotic Properties of Strain KMU01
3.4.3. Strain KMU01 as a Starter Candidate
4. Conclusions
Supplementary Materials
Author Contributions
Funding
Institutional Review Board Statement
Informed Consent Statement
Data Availability Statement
Acknowledgments
Conflicts of Interest
References
- Jung, J.Y.; Lee, S.H.; Jeon, C.O. Kimchi microflora: History, current status, and perspectives for industrial kimchi production. Appl. Miclobiol. Biotechnol. 2014, 98, 2385–2393. [Google Scholar] [CrossRef]
- Hong, S.W.; Choi, Y.J.; Lee, H.W.; Yang, J.H.; Lee, M.A. Microbial community structure of Korean cabbage kimchi and ingredients with denaturing gradient gel electrophoresis. J. Microbiol. Biotechnol. 2016, 26, 1057–1062. [Google Scholar] [CrossRef]
- An, D.; Kim, H.-R.; Jeong, D.W.; Caldwell, J.M.; Lee, J.H. Bacterial community monitoring of commercial kimchi produced in Korea and China with evidence of Bacilli spore formation during fermentation. Microbiol. Biotechnol. Lett. 2014, 42, 121–130. [Google Scholar] [CrossRef]
- Park, E.J.; Chun, J.; Cha, C.J.; Park, W.S.; Jeon, C.O.; Bae, J.W. Bacterial community analysis during fermentation of ten representative kinds of kimchi with barcoded pyrosequencing. Food Microbiol. 2012, 30, 197–204. [Google Scholar] [CrossRef] [PubMed]
- Cho, M.S.; Jin, Y.J.; Kang, B.K.; Park, Y.K.; Kim, C.; Park, D.S. Understanding the ontogeny and succession of Bacillus velezensis and B. subtilis subsp. subtilis by focusing on kimchi fermentation. Sci. Rep. 2018, 8, 7045. [Google Scholar] [CrossRef] [PubMed]
- Choi, Y.H.; Cho, S.S.; Simkhada, J.R.; Yoo, J.C. A novel thermotolerant and acidotolerant peptide produced by a Bacillus strain newly isolated from a fermented food (kimchi) shows activity against multidrug-resistant bacteria. Int. J. Antimicrob. Agents 2012, 40, 80–83. [Google Scholar] [CrossRef] [PubMed]
- Jeon, H.L.; Lee, N.K.; Yang, S.J.; Kim, W.S.; Paik, H.D. Probiotic characterization of Bacillus subtilis P223 isolated from kimchi. Food Sci. Biotechnol. 2017, 26, 1641–1648. [Google Scholar] [CrossRef]
- Cutting, S.M. Bacillus probiotics. Food Microbiol. 2011, 28, 214–220. [Google Scholar] [CrossRef]
- Hong, H.A.; Duc le, H.; Cutting, S.M. The use of bacterial spore formers as probiotics. FEMS Microbiol. Rev. 2005, 29, 813–835. [Google Scholar] [CrossRef]
- Msarah, M.J.; Ibrahim, I.; Hamid, A.A.; Aqma, W.S. Optimisation and production of alpha amylase from thermophilic Bacillus spp. and its application in food waste biodegradation. Heliyon 2020, 6, e04183. [Google Scholar] [CrossRef]
- Oguntoyinbo, F.A.; Sanni, A.I.; Franz, C.M.; Holzapfel, W.H. In vitro fermentation studies for selection and evaluation of Bacillus strains as starter cultures for the production of okpehe, a traditional African fermented condiment. Int. J. Food Microbiol. 2007, 113, 208–218. [Google Scholar] [CrossRef]
- Jeong, D.W.; Heo, S.; Lee, B.; Lee, H.; Jeong, K.; Her, J.Y.; Lee, K.G.; Lee, J.H. Effects of the predominant bacteria from meju and doenjang on the production of volatile compounds during soybean fermentation. Int. J. Food Microbiol. 2017, 262, 8–13. [Google Scholar] [CrossRef]
- Jeong, D.W.; Lee, H.; Jeong, K.; Kim, C.T.; Shim, S.T.; Lee, J.H. Effects of starter candidates and NaCl on the production of volatile compounds during soybean fermentation. J. Microbiol. Biotechnol. 2019, 29, 191–199. [Google Scholar] [CrossRef]
- Sung, M.-H.; Kwak, M.-S.; Baek, S.-Y. Novel halophilic Bacillus polyfermenticus strain for producing halotolerant gamma-glutamyl transpeptidase. Korean patent 1020200001451, 2020. [Google Scholar]
- Parte, A.C.; Carbasse, J.S.; Meier-Kolthoff, J.P.; Reimer, L.C.; Goker, M. List of Prokaryotic names with Standing in Nomenclature (LPSN) moves to the DSMZ. Int. J. Syst. Evol. Microbiol. 2020, 70, 5607–5612. [Google Scholar] [CrossRef]
- Jeong, H.; Kim, J.; Choi, S.K.; Pan, J.G. Genome sequence of the probiotic strain Bacillus velezensis variant polyfermenticus GF423. Microbiol. Resour. Announc. 2018, 7, e01000-18. [Google Scholar] [CrossRef]
- Courtay, C.; Oster, T.; Michelet, F.; Visvikis, A.; Diederich, M.; Wellman, M.; Siest, G. γ-Glutamyltransferase: Nucleotide sequence of the human pancreatic cDNA: Evidence for a ubiquitous γ-glutamyltransferase polypeptide in human tissues. Biochem. Pharmacol. 1992, 43, 2527–2533. [Google Scholar] [CrossRef]
- Suzuki, H.; Kajimoto, Y.; Kumagai, H. Improvement of the bitter taste of amino acids through the transpeptidation reaction of bacterial γ-glutamyltranspeptidase. J. Agric. Food Chem. 2002, 50, 313–318. [Google Scholar] [CrossRef]
- Jeong, D.W.; Heo, S.; Ryu, S.; Blom, J.; Lee, J.H. Genomic insights into the virulence and salt tolerance of Staphylococcus equorum. Sci. Rep. 2017, 7, 5383. [Google Scholar] [CrossRef]
- Tatusova, T.; DiCuccio, M.; Badretdin, A.; Chetvernin, V.; Nawrocki, E.P.; Zaslavsky, L.; Lomsadze, A.; Pruitt, K.D.; Borodovsky, M.; Ostell, J. NCBI prokaryotic genome annotation pipeline. Nucleic Acids Res. 2016, 44, 6614–6624. [Google Scholar] [CrossRef]
- Tatusov, R.L.; Koonin, E.V.; Lipman, D.J. A genomic perspective on protein families. Science 1997, 278, 631–637. [Google Scholar] [CrossRef]
- Goris, J.; Konstantinidis, K.T.; Klappenbach, J.A.; Coenye, T.; Vandamme, P.; Tiedje, J.M. DNA-DNA hybridization values and their relationship to whole-genome sequence similarities. Int. J. Syst. Evol. Microbiol. 2007, 57, 81–91. [Google Scholar] [CrossRef]
- Blom, J.; Kreis, J.; Spanig, S.; Juhre, T.; Bertelli, C.; Ernst, C.; Goesmann, A. EDGAR 2.0: An enhanced software platform for comparative gene content analyses. Nucleic. Acids Res. 2016, 44, W22–W28. [Google Scholar] [CrossRef]
- Aziz, R.K.; Bartels, D.; Best, A.A.; DeJongh, M.; Disz, T.; Edwards, R.A.; Formsma, K.; Gerdes, S.; Glass, E.M.; Kubal, M.; et al. The RAST Server: Rapid annotations using subsystems technology. BMC Genom. 2008, 9, 75. [Google Scholar] [CrossRef]
- Jeong, D.W.; Lee, B.; Lee, H.; Jeong, K.; Jang, M.; Lee, J.H. Urease characteristics and phylogenetic status of Bacillus paralicheniformis. J. Microbiol. Biotechnol. 2018, 28, 1992–1998. [Google Scholar] [CrossRef]
- Kumar, S.; Stecher, G.; Tamura, K. MEGA7: Molecular evolutionary genetics analysis Version 7.0 for Bigger Datasets. Mol. Biol. Evol. 2016, 33, 1870–1874. [Google Scholar] [CrossRef]
- Abbas, B.A.; Khudor, M.H.; Saeed, B.M.S. Detection of hbl, nhe and bceT toxin genes in Bacillus cereus isolates by multiplex PCR. Int. J. Curr. Microbiol. App. Sci. 2014, 3, 1009–1016. [Google Scholar]
- Dinges, M.M.; Orwin, P.M.; Schlievert, P.M. Exotoxins of Staphylococcus aureus. Clin. Microbiol. Rev. 2000, 13, 16–34. [Google Scholar] [CrossRef] [PubMed]
- Jeong, D.W.; Cho, H.; Lee, H.; Li, C.; Garza, J.; Fried, M.; Bae, T. Identification of the P3 promoter and distinct roles of the two promoters of the SaeRS two-component system in Staphylococcus aureus. J. Bacteriol. 2011, 193, 4672–4684. [Google Scholar] [CrossRef] [PubMed]
- Clinical Laboratosy Standards Institute. Performance Standards for Antimicrobial Susceptibility Testing: Seventeenth Informational Supplement; CLSI: Wayne, PA, USA, 2007. [Google Scholar]
- EFSA. Opinion of the scientific committee on a request from EFSA on the introduction of a qualified presumption of safety (QPS) approach for assessment of selected microorganisms referred to TFSA. EFSA 2005, 587, 1–16. [Google Scholar]
- EFSA. Scientific opinion on the update of the list of QPS-recommended biological agents intentionally added to food or feed as notified to EFSA. EFSA 2017, 15, 4664. [Google Scholar]
- Dunlap, C.A.; Kim, S.J.; Kwon, S.W.; Rooney, A.P. Bacillus velezensis is not a later heterotypic synonym of Bacillus amyloliquefaciens; Bacillus methylotrophicus, Bacillus amyloliquefaciens subsp. plantarum and ‘Bacillus oryzicola’ are later heterotypic synonyms of Bacillus velezensis based on phylogenomics. Int. J. Syst. Evol. Microbiol. 2016, 66, 1212–1217. [Google Scholar] [CrossRef] [PubMed]
- Schroeder, M.; Brooks, B.D.; Brooks, A.E. The complex relationship between virulence and antibiotic resistance. Genes 2017, 8, 39. [Google Scholar] [CrossRef] [PubMed]
- Heo, S.; Bae, T.; Lee, J.H.; Jeong, D.W. Transfer of a lincomycin-resistant plasmid between coagulase-negative staphylococci during soybean fermentation and mouse intestine passage. FEMS Microbiol. Lett. 2019, 366. [Google Scholar] [CrossRef]
- Huddleston, J.R. Horizontal gene transfer in the human gastrointestinal tract: Potential spread of antibiotic resistance genes. Infect. Drug Resist. 2014, 7, 167–176. [Google Scholar] [CrossRef]
- Munita, J.M.; Arias, C.A. Mechanisms of antibiotic resistance. Microbiol. Spectr. 2016, 4, VMBF-0016-2015. [Google Scholar] [CrossRef]
- Card, R.M.; Warburton, P.J.; MacLaren, N.; Mullany, P.; Allan, E.; Anjum, M.F. Application of microarray and functional-based screening methods for the detection of antimicrobial resistance genes in the microbiomes of healthy humans. PLoS ONE 2014, 9, e86428. [Google Scholar] [CrossRef]
- Davies, J.; Davies, D. Origins and evolution of antibiotic resistance. Microbiol. Mol. Biol. Rev. 2010, 74, 417–433. [Google Scholar] [CrossRef]
- Harding, I.; Simpson, I. Fluoroquinolones: Is there a different mechanism of action and resistance against Streptococcus pneumoniae? J. Chemother. 2000, 12 (Suppl. S4), 7–15. [Google Scholar] [CrossRef]
- Zhang, L.; Li, X.Z.; Poole, K. SmeDEF multidrug efflux pump contributes to intrinsic multidrug resistance in Stenotrophomonas maltophilia. Antimicrob. Agents Chemother. 2001, 45, 3497–3503. [Google Scholar] [CrossRef]
- Ha, G.; Im, S.; Shin, S.-J.; Ryu, M.; Kim, J.W.; Jeong, S.-W.; Jeong, D.-Y. Complete genome sequence of Bacillus velezensis SRCM102755, a high menaquinone-7 producer, isolated from Doenjang. Korean J. Microbiol. 2020, 56, 74–75. [Google Scholar]
- Jeong, D.W.; Kim, H.R.; Jung, G.; Han, S.; Kim, C.T.; Lee, J.H. Bacterial community migration in the ripening of doenjang, a traditional Korean fermented soybean food. J. Microbiol. Biotechnol. 2014, 24, 648–660. [Google Scholar] [CrossRef]
- Lee, J.H.; Jeong, D.W.; Kim, M.K. Influence of bacterial starter cultures on the sensory characteristics of doenjang, a fermented soybean paste, and their impact on consumer hedonic perception. J. Sens. Stud. 2019, 34, e12508. [Google Scholar] [CrossRef]
- Schwan, W.R.; Wetzel, K.J. Osmolyte transport in Staphylococcus aureus and the role in pathogenesis. World J. Clin. Infect. Dis. 2016, 6, 22–27. [Google Scholar] [CrossRef]
- Romantsov, T.; Guan, Z.; Wood, J.M. Cardiolipin and the osmotic stress responses of bacteria. Biochim. Biophys. Acta-Biomembr. 2009, 1788, 2092–2100. [Google Scholar] [CrossRef]
- Kanemasa, Y.; Yoshioka, T.; Hayashi, H. Alteration of the phospholipid composition of Staphylococcus aureus cultured in medium containing NaCl. Biochim. Biophys. Acta-Biomembr. 1972, 280, 444–450. [Google Scholar]
- Binda, S.; Hill, C.; Johansen, E.; Obis, D.; Pot, B.; Sanders, M.E.; Tremblay, A.; Ouwehand, A.C. Criteria to qualify microorganisms as “Probiotic” in foods and dietary supplements. Front. Microbiol. 2020, 11, 1662. [Google Scholar] [CrossRef] [PubMed]
- Ruiz, L.; Ruas-Madiedo, P.; Gueimonde, M.; de Los Reyes-Gavilan, C.G.; Margolles, A.; Sanchez, B. How do bifidobacteria counteract environmental challenges? Mechanisms involved and physiological consequences. Genes Nutr. 2011, 6, 307–318. [Google Scholar] [CrossRef] [PubMed]
- Yang, Y.; Liu, Y.; Zhou, S.; Huang, L.; Chen, Y.; Huan, H. Bile salt hydrolase can improve Lactobacillus plantarum survival in gastrointestinal tract by enhancing their adhesion ability. FEMS Microbiol. Lett. 2019, 366. [Google Scholar] [CrossRef] [PubMed]
- Granato, D.; Bergonzelli, G.E.; Pridmore, R.D.; Marvin, L.; Rouvet, M.; Corthesy-Theulaz, I.E. Cell surface-associated elongation factor Tu mediates the attachment of Lactobacillus johnsonii NCC533 (La1) to human intestinal cells and mucins. Infect. Immun. 2004, 72, 2160–2169. [Google Scholar] [CrossRef] [PubMed]
- Henderson, B.; Nair, S.; Pallas, J.; Williams, M.A. Fibronectin: A multidomain host adhesin targeted by bacterial fibronectin-binding proteins. FEMS Microbiol. Rev. 2011, 35, 147–200. [Google Scholar] [CrossRef]
- Salas-Jara, M.J.; Ilabaca, A.; Vega, M.; Garcia, A. Biofilm forming Lactobacillus: New challenges for the development of probiotics. Microorganisms 2016, 4, 35. [Google Scholar] [CrossRef] [PubMed]
- Haiko, J.; Westerlund-Wikstrom, B. The role of the bacterial flagellum in adhesion and virulence. Biology 2013, 2, 1242–1267. [Google Scholar] [CrossRef] [PubMed]
- Dons, L.; Eriksson, E.; Jin, Y.; Rottenberg, M.E.; Kristensson, K.; Larsen, C.N.; Bresciani, J.; Olsen, J.E. Role of flagellin and the two-component CheA/CheY system of Listeria monocytogenes in host cell invasion and virulence. Infect. Immun. 2004, 72, 3237–3244. [Google Scholar] [CrossRef]
- Chatterjee, S.; Chatterjee, S.; Lad, S.J.; Phansalkar, M.S.; Rupp, R.H.; Ganguli, B.N.; Fehlhaber, H.W.; Kogler, H. Mersacidin, a new antibiotic from Bacillus. Fermentation, isolation, purification and chemical characterization. J. Antibiot. 1992, 45, 832–838. [Google Scholar] [CrossRef]
- Hemarajata, P.; Versalovic, J. Effects of probiotics on gut microbiota: Mechanisms of intestinal immunomodulation and neuromodulation. Ther. Adv. Gastroenterol. 2013, 6, 39–51. [Google Scholar] [CrossRef]
- Zhang, H.; Kovacs-Nolan, J.; Kodera, T.; Eto, Y.; Mine, Y. γ-Glutamyl cysteine and γ-glutamyl valine inhibit TNF-α signaling in intestinal epithelial cells and reduce inflammation in a mouse model of colitis via allosteric activation of the calcium-sensing receptor. Biochim. Biophys. Acta-Biomembr. 2015, 1852, 792–804. [Google Scholar] [CrossRef]
- Lee, N.R.; Go, T.H.; Lee, S.M.; Jeong, S.Y.; Park, G.T.; Hong, C.O.; Son, H.J. In vitro evaluation of new functional properties of poly-γ-glutamic acid produced by Bacillus subtilis D7. Saudi J. Biol. Sci. 2014, 21, 153–158. [Google Scholar] [CrossRef]
- Frerot, E.; Chen, T. Identification and quantitation of new glutamic acid derivatives in soy sauce by UPLC/MS/MS. Chem. Biodivers. 2013, 10, 1842–1850. [Google Scholar] [CrossRef] [PubMed]
- Toelstede, S.; Hofmann, T. Kokumi-active glutamyl peptides in cheeses and their biogeneration by Penicillium roquefortii. J. Agric. Food chem. 2009, 57, 3738–3748. [Google Scholar] [CrossRef] [PubMed]
- Fujita, M.; Ohnishi, K.; Takaoka, S.; Ogasawara, K.; Fukuyama, R.; Nakamuta, H. Antihypertensive effects of continuous oral administration of nattokinase and its fragments in spontaneously hypertensive rats. Biol. Pharm. Bull. 2011, 34, 1696–1701. [Google Scholar] [CrossRef] [PubMed]
- Moon, S.; Park, Y.; Kim, I.; Chang, H. Isolation and characterization of Bacillus velezensis SS360-1 from seed soy sauce. Korean J. Soc. Community Living Sci. 2018, 29, 49–58. [Google Scholar] [CrossRef]
- Yoo, S.K.; Cho, W.H.; Kang, S.M.; Lee, S.H. Isolation and identification of microorganisms in Korean traditional soybean paste and soybean sauce. Korean J. Appl. Microbiol. Biotehcnol. 1999, 27, 113–117. [Google Scholar]
- Choi, K.-K.; Cui, C.-B.; Ham, S.-S.; Lee, D.-S. Isolation, identification and growth characteristics of main strain related to meju fermentation. J. Korean Soc. Food Sci. Nutr. 2003, 32, 818–824. [Google Scholar]
- Amino, Y.; Wakabayashi, H.; Akashi, S.; Ishiwatari, Y. Structural analysis and taste evaluation of γ-glutamyl peptides comprising sulfur-containing amino acids. Biosci. Biotechnol. Biochem. 2018, 82, 383–394. [Google Scholar] [CrossRef] [PubMed]

| Gene Locus | KEGG | Product | COG | Presence of Gene in Five B. velezensis Genomes | ||||
|---|---|---|---|---|---|---|---|---|
| 10075 | CMT-6 | DKU_NT_04 | NRRL B-41580 | SRCM102741 | ||||
| IM712_RS02140 | K03297 | Multidrug resistance protein EbrA | P | ● | ● | ● | ● | ● |
| IM712_RS02790 | K07552 | Multidrug resistance protein | P | ● | ● | ● | ● | ● |
| IM712_RS02950 | K18926 | Lincomycin resistance protein LmrB | P | ● | ● | ● | ● | ● |
| IM712_RS08810 | K08153 | Multidrug resistance protein | G | ● | ● | ● | ● | ● |
| IM712_RS11555 | K08168 | Tetracycline resistance protein | G | ● | ● | ● | ● | |
| IM712_RS14095 | K03327 | Probable multidrug resistance protein NorM | V | ● | ● | ● | ● | ● |
| IM712_RS14445 | K03327 | Probable multidrug resistance protein YoeA | V | ● | ● | ● | ● | ● |
| IM712_RS15085 | K11814 | Multidrug resistance protein EbrA | P | ● | ● | ● | ● | ● |
| IM712_RS15090 | K11815 | Multidrug resistance protein EbrB | P | ● | ● | ● | ● | ● |
| IM712_RS17200 | K18925 | Multidrug resistance protein YkkD | P | ● | ● | ● | ● | ● |
| IM712_RS17205 | K18924 | Multidrug resistance protein YkkC | P | ● | ● | ● | ● | ● |
| IM712_RS18380 | K08153 | Multidrug resistance protein | G | ● | ● | ● | ● | ● |
| IM712_RS18790 | K06147 | Probable multidrug resistance ABC transporter ATP binding | V | ● | ● | ● | ● | ● |
| IM712_RS18795 | K06147 | Probable multidrug resistance ABC transporter ATP binding | V | – | ● | ● | ● | ● |
| Indicator Strain | Anti-Bacterial Activity | |
|---|---|---|
| Gram-positive | ||
| Bacillus cereus KCCM 11341 | ++ | |
| Listeria monocytogenes ATCC 19111 | ++ | |
| Staphylococcus aureus ATCC 12692 | ++ | |
| Gram-negative | ||
| Alcaligenes xylosoxidans KCCM 40240 | + | |
| Escherichia coli O157:H7 EDL 933 | + | |
| Flavobacterium sp. KCCM 11374 | ‒ | |
| Salmonella enterica KCCM 11862 | ‒ | |
| Vibrio parahaemolyticus ATCC 17802 | + | |
Publisher’s Note: MDPI stays neutral with regard to jurisdictional claims in published maps and institutional affiliations. |
© 2021 by the authors. Licensee MDPI, Basel, Switzerland. This article is an open access article distributed under the terms and conditions of the Creative Commons Attribution (CC BY) license (http://creativecommons.org/licenses/by/4.0/).
Share and Cite
Heo, S.; Kim, J.-H.; Kwak, M.-S.; Sung, M.-H.; Jeong, D.-W. Functional Annotation Genome Unravels Potential Probiotic Bacillus velezensis Strain KMU01 from Traditional Korean Fermented Kimchi. Foods 2021, 10, 563. https://doi.org/10.3390/foods10030563
Heo S, Kim J-H, Kwak M-S, Sung M-H, Jeong D-W. Functional Annotation Genome Unravels Potential Probiotic Bacillus velezensis Strain KMU01 from Traditional Korean Fermented Kimchi. Foods. 2021; 10(3):563. https://doi.org/10.3390/foods10030563
Chicago/Turabian StyleHeo, Sojeong, Jong-Hoon Kim, Mi-Sun Kwak, Moon-Hee Sung, and Do-Won Jeong. 2021. "Functional Annotation Genome Unravels Potential Probiotic Bacillus velezensis Strain KMU01 from Traditional Korean Fermented Kimchi" Foods 10, no. 3: 563. https://doi.org/10.3390/foods10030563
APA StyleHeo, S., Kim, J.-H., Kwak, M.-S., Sung, M.-H., & Jeong, D.-W. (2021). Functional Annotation Genome Unravels Potential Probiotic Bacillus velezensis Strain KMU01 from Traditional Korean Fermented Kimchi. Foods, 10(3), 563. https://doi.org/10.3390/foods10030563

